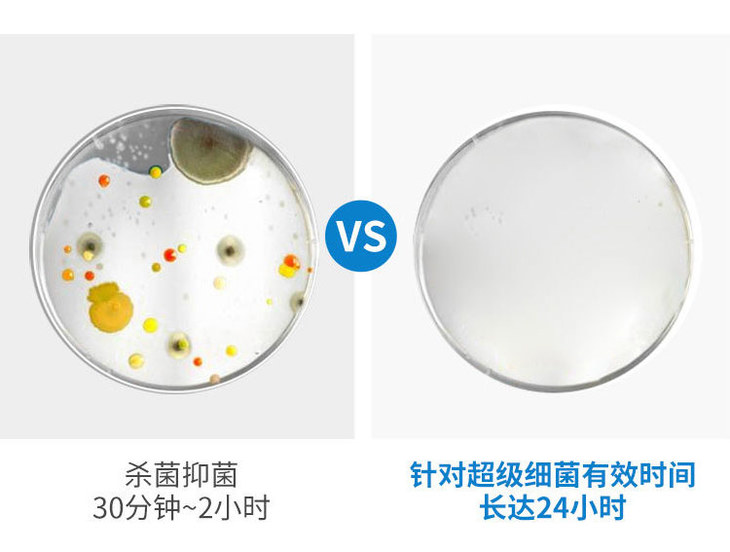

现货 现喜檀香免洗礼佛净手凝胶 佛堂寺庙斋堂清净 净手 抑菌消毒
¥19.90
-
天语龙吟藏香旗舰店
(微信公众号认证)
- 2002年天语龙吟实体店诞生于天府之国成都,以三殊胜摄持,虔心发愿弘扬护持正法,依经教、戒律谨慎取舍,臻选清净如法之精品法宝,为您提供便利助缘。
- 扫描二维码,访问我们的微信店铺
- 随时随地的购物、客服咨询、查询订单和物流...
现货 现喜檀香免洗礼佛净手凝胶 佛堂寺庙斋堂清净 净手 抑菌消毒
1. 打开微信,扫一扫左侧二维码
2. 点击右上角图标

3. 发送给朋友、分享到朋友圈、收藏

打开微信,扫一扫
或搜索微信号:tianyulongyin
1. 打开微信,扫一扫左侧二维码
2. 点击右上角图标

3. 发送给朋友、分享到朋友圈、收藏